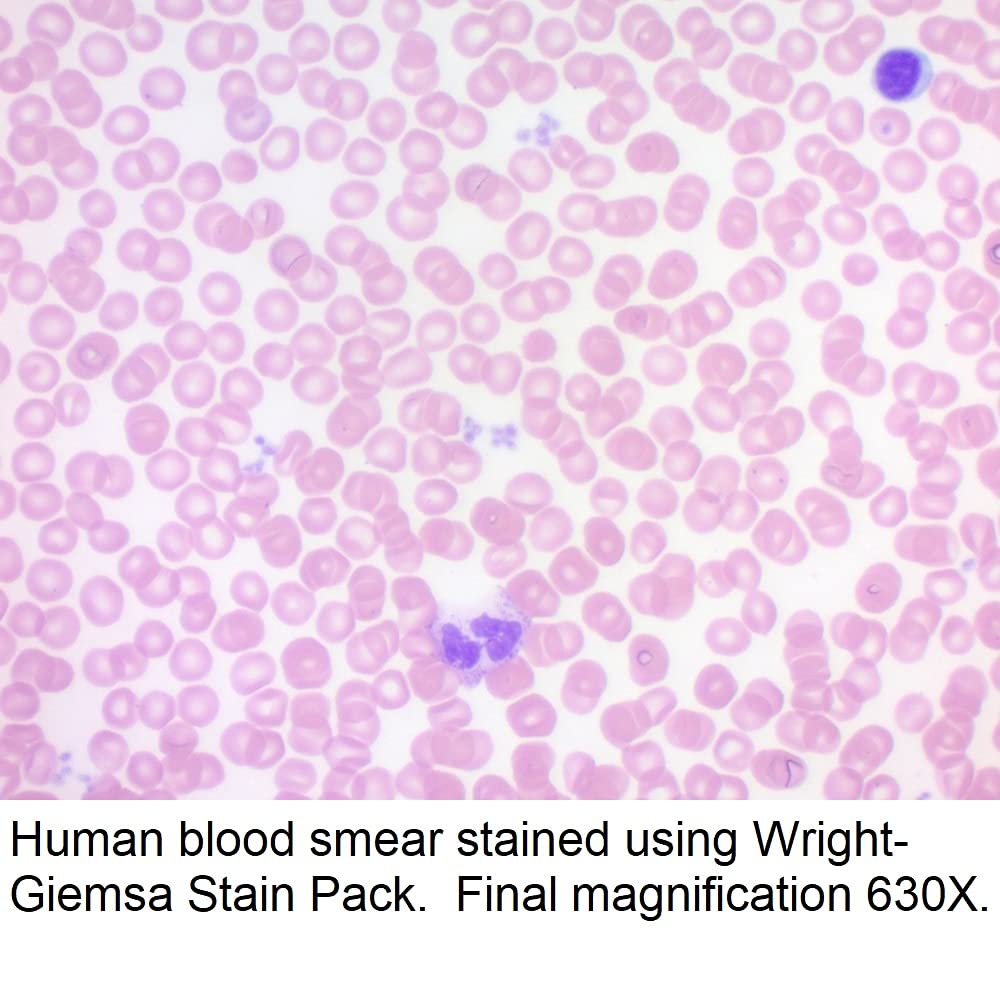
Wright-Giemsa Stain Pack, 500ml

Wright-Giemsa Stain Pack, 500ml
$71.23
Price when purchased online
Free shipping
Free 30-day returns
Sold and shipped by wafi-egypt.com
We aim to show you accurate product information. Manufacturers, suppliers and others provide what you see here.
$71.23
Price when purchased online
Free shipping
Free 30-day returns
Sold and shipped by wafi-egypt.com
Free 30-day returns Details
Product details
| Management number | 211770924 | Release Date | 2026/04/04 | List Price | $28.49 | Model Number | 211770924 | ||
|---|---|---|---|---|---|---|---|---|---|
| Category | |||||||||
Wright-Giemsa Stain Pack is intended to be used for differential staining of blood smears, bone marrow and blood parasites. Erythrocytes:Pink-Tan Leukocytes:Blue-Purple Neutrophils:Light Purple granules in cytoplasm. Eosinophils:Bright Red-Red/Orange granules in cytoplasm. Basophils:Deep Purple granules in cytoplasm. Platelets:Violet-Purple granules in light blue cytoplasm.
- Hematology applications
| Manufacturer | Tyr Scientific LLC |
|---|
Correction of product information
If you notice any omissions or errors in the product information on this page, please use the correction request form below.
Correction Request Form